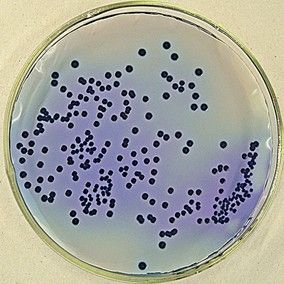
人型支原體

特點
 人型支原體
人型支原體支原體用普通染色法不易著色,用姬姆薩染色很淺,革蘭染色為陰性。人型支原體可在雞胚絨毛尿囊膜上或細胞培養中生長。
用培養基培養。營養要求比細菌高。由於它沒有細胞壁,因此對影響細胞壁合成的抗生素,如青黴素等不敏感,但紅黴素、四環素、卡那黴素、鏈黴素、氯黴素等作用於核蛋白體的抗生素,可抑制或影響支原體的蛋白質合成,特別是含PHMB殺菌成分的嬌妍潔陰洗液有殺傷支原體作用,支原體對熱抵抗力差,通常55℃經15分鐘處理可使之滅活。
石碳酸,來蘇兒易將其殺死。在培養基中置入脲素並以硫酸錳作指示劑極易與其他支原體作出鑑別。
流行病學
由於診斷條件所限和命名上的問題。國內尚無系統的人群調查資料,支原體可存在於健康攜帶者,而在性亂者、同性戀、妓女、淋病患者中檢出率較高,我國報導7個地區健康人攜帶率為解脲支原體(UU)占10.59%,人型支原體(MH)占5.34%。性亂者UU的檢出率為71.7%,MH為19.57%。調查表明,性伴數越多,性活躍指數越大,UU和MH感染率越高。
傳播途徑
成人主要通過性接觸傳播,新生兒則由母親生殖道分娩時感染。成人男性的感染部位在尿道黏膜,女性感染部位在宮頸。新生兒主要引起結膜炎和肺炎。
感染原因
人型支原體
人型支原體長期的或反覆的衣原體和支原體感染會破壞子宮頸和輸卵管內的內膜層,造成不孕。衣原體和支原體的感染大多數是通過性行為傳染的,有杜絕互相傳染而反覆感染,就應該對性伴侶同時治療。
有人做了調查,其中男性支原體感染率為33。7%,女性支原體感染率為74。4%,經統計學檢驗P<0。05,可認為支原體感染在性別上有顯著性差異,女性高於男性。人型支原體感染原因可能與男女生殖系統的結構差別有關。由於男性的外生殖道與尿道重合,細胞外寄生菌容易被尿液衝掉,而女性的生殖道與尿道為單獨的生理結構,缺乏“尿衝力的保護”,故較女性易受感染。雖然男性較女性不易感染,但本次調查顯示男性的感染率依然較高,達37。7%,所以男性同樣應重視支原體的預防。
感染誤區
現在因為“人型支原體陽性”作為人型支原體感染被當做“性病”治療“反覆不愈”的,在醫院門診上屢見不鮮。 那么,支原體到底是一種什麼東西呢?我們知道,人體內並不是一個絕對無菌的環境,僅在男性尿道、女性陰道內就有20多種微生物生存。這些微生物有好的,有壞的,它們相互制約,構成一個平衡狀態。人型支原體就是其中一類微生物,它們比細菌小,比病毒大,人型支原體(mycoplasma hominis)對外界環境抵抗力弱,45℃15min即可被殺死。不論是嬰兒還是老人,生殖道中均可能有人型支原體的寄居,在成年男女生殖道中的檢出率非常高。調查表明,34%的正常男性尿道中可檢出支原體,60.9%的女性宮頸中可檢出支原體,而這些人沒有任何症狀。這說明這種“支原體陽性”是正常情況,不需要任何治療。
相關疾病
那么為什麼許多診所、醫院要對支原體陽性的人群進行治療呢?這是因為,確實有研究認為,支原體與非淋菌性尿道炎、附睪炎等性傳播疾病有關,與前列腺炎、尿道炎、腎盂腎炎、盆腔炎等生殖泌尿系統疾病也有一定相關性。因此,許多醫院開展了對支原體的檢查和治療。而隨著檢查技術的改進,檢查的方法敏感性也很高,支原體陽性檢出率隨之增高。
臨床表現
潛伏期為1-3周,典型的急性期症狀與其他非淋病性生殖泌尿系統感染相似,表現為尿道刺痛,不同程度的尿急及尿頻、排尿刺痛,特別是當尿液較為濃縮的時候明顯。尿道口輕度紅腫,分泌物稀薄,量少,為漿液性或膿性,多需用力擠壓尿道才見分泌物溢出,常於晨起尿道口有少量粘液性分泌物或僅有痂膜封口,或見污穢褲襠。約有三分一的病人可無任何自覺症狀。只是在例行檢查時才被發現。50%病人初診被忽略或誤診,約有10%-20%的患者同時有淋球菌雙重感染。
男性感染人型支原體,亞急性期常合併前列腺感染,患者常出現會陰部脹痛、腰酸、雙股內側不適感或在做提肛動作時有自會陰向股內側發散的刺痛感。肛診時前列腺縱溝不明顯或表面類似核桃殼凹凸不平,少數病例B型超音波診斷可證實不同程度的增大。合併副睪炎者不多見。
女性患者多見以子宮頸為中心擴散的生殖系炎症。多數無明顯自覺症狀,少數重症病人有陰道墜感,當感染擴及尿道時,尿頻、尿急是引起病人注意的主要症狀。感染局限在子宮頸,表現為白帶增多、混濁、子宮頸水腫、充血或表面糜爛。感染擴及尿道表現為尿道口潮紅、充血、擠壓尿道可有少量分泌物外溢,但很少有壓痛出現。人型支原體感染常見的合併症為輸卵管炎,少數患者可出現子宮內膜炎及盆腔炎。
感染對策
 人型支原體檢測
人型支原體檢測情況一:單純從尿道、陰道中檢出支原體,而沒有任何伴隨的症狀。
對策:不必理它,無須治療。
分析:這種“支原體陽性”是正常的攜帶狀態,並不意味著致病。如果醫生為你進行全身的微生物培養,至少可以分離出數十種病原體,但這並不代表你有數十種疾病。這種支原體陽性並不等於支原體感染,支原體可以與人共同生存而不表現出感染徵象。而且,作為正常人群,即便經過藥物治療降低了其攜帶率,但經過一段時間的正常性行為,攜帶率也會恢復原有水平。因此,不要恐慌,更不要濫用藥物治療,日常的清潔保養用Ph4弱酸配方的女性護理液已足夠。
情況二:檢出支原體,同時有生殖道炎症或合併性傳播疾病。
對策:進行抗支原體的治療。
分析:這種“支原體陽性”屬於感染狀態,需要積極治療,如用中藥利尿消炎丸。經過治療,降低了支原體攜帶率,有助於加速生殖道疾病或性傳播疾病的痊癒。
情況三:孕前檢查發現支原體陽性。
對策:有症狀或有生育要求時,建議男女雙方同時檢查,支原體陽性者應正規治療。
分析:支原體檢查是孕前優生五項檢查之一,支原體可以影響精子的活力,可以感染胎兒和新生兒,引起早產、死胎、低體重兒、新生兒腦膜炎等。出於優生優育的考慮,支原體陽性應治療。正規治療結束一周后,支原體培養陰性,可認為已治癒,可以開始準備生育。
治療
支原體感染可在醫生指導下選擇服用阿奇、羅紅黴素、美滿黴素、強力黴素、左氟沙星等廣譜抗生素療法進行治療,並且強調要連續不間斷用藥,要規則、定量、徹底治療。治療後10~20天複查兩次均為陰性,並且臨床症狀消失為治癒。
預防措施
人型支原體需要雙方同時注意預防,在同房前後要注意清洗。如果發現有一方有人型支原體,需去醫院進行檢查和治療。20天一個療程,在治療期間不能同房,因為不是一個個體會引起交叉感染。當治療後,一次月經過去,複查最佳,停藥7天后進行複查。如果顯示為陰性,就可以同房了,同房前後雙方都要注意清洗。
夫婦雙方應在準備懷孕前進行人型支原體檢測,若存在人型支原體感染,應於治癒後再懷孕;其次,妊娠早期檢測,若檢測為陽性,應及時治療,以免對胎兒構成損害。未孕婦女可服用美滿黴素、紅黴素等藥物,孕婦只限用紅黴素治療。紅黴素副作用小,人型支原體是一種通過性接觸傳播的疾病,也存在間接性感染,因此,夫婦雙方重視性衛生,杜絕不潔性生活,對預防人型支原體感染具有十分重要的意義。
注意事項
1.在沒有治癒前避免性行為。
2.禁酒、不吃辛辣食物,多飲水。
3.家庭中做好必要的隔離,浴巾、臉盆、浴缸、便器等分開使用,或用後消毒。
4.配偶或性伴侶應到醫院作檢查和治療。
5.今後要注意安全性行為,高危時應正確使用保險套。
6.日常陰部清潔使用pH4弱酸性女性護理液。
7.建議治療同時,需要注重個人生活衛生,病情為緩解前最好不要進行房事,以免交叉感染。

